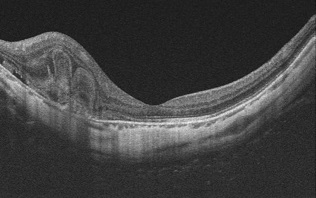

強度近視に伴う脈絡膜新生血管とは
近視とは大抵の場合、眼球が前後方向に拡大しすぎた為に、遠くへピントが合わなくなった状態を意味します。主に遺伝などの原因でこの近視性の変化、すなわち前後方向の眼球の拡大が強くなると、眼球の壁てある強膜ととともに網膜とその下の脈絡膜(血管で構成されたスポンジ状の膜)などが全て、薄く引き延ばされてしまいます。すると網膜と脈絡膜を隔てるブルッフ膜という部分に亀裂ができ、その亀裂を通って脈絡膜から新生血管という異常な血管が網膜の下に伸びてくる場合があります。この病気では、そこから出血や滲出変化(網膜が水浸しになる)を引き起こし、ものが歪んで見えるようになったり視界の中央が見えなくなります。

強度近視に伴う脈絡膜新生血管の診断・治療方針について
・診断: 加齢黄斑変性に類似していますが、強度近視による眼底の特徴や光干渉断層計(OCT)画像における特徴を慎重に見極めることで診断可能です。黄斑部の眼底に出血があっても脈絡膜新生血管がない場合(単純出血)もあり得ますので、光干渉断層血管撮影(OCTA)で脈絡膜新生血管の有無を調べます。
・治療: 加齢黄斑変性や網膜静脈閉塞症による黄斑浮腫と同様に、抗VEGF薬の眼内注射治療が第一選択です。諸事情で受けられない方は、ステロイド薬の後部テノン嚢下注射(白目の部分から眼球に沿って眼球の外側奥の方に注射)を行うこともあります。治療の時期が遅れると、治療して滲出変化が改善しても視力が回復しづらくなってしまいますので、早めの治療が必要です。

※上記症例に抗VEGF薬注射を行って2カ月目の眼底写真とOCT画像。